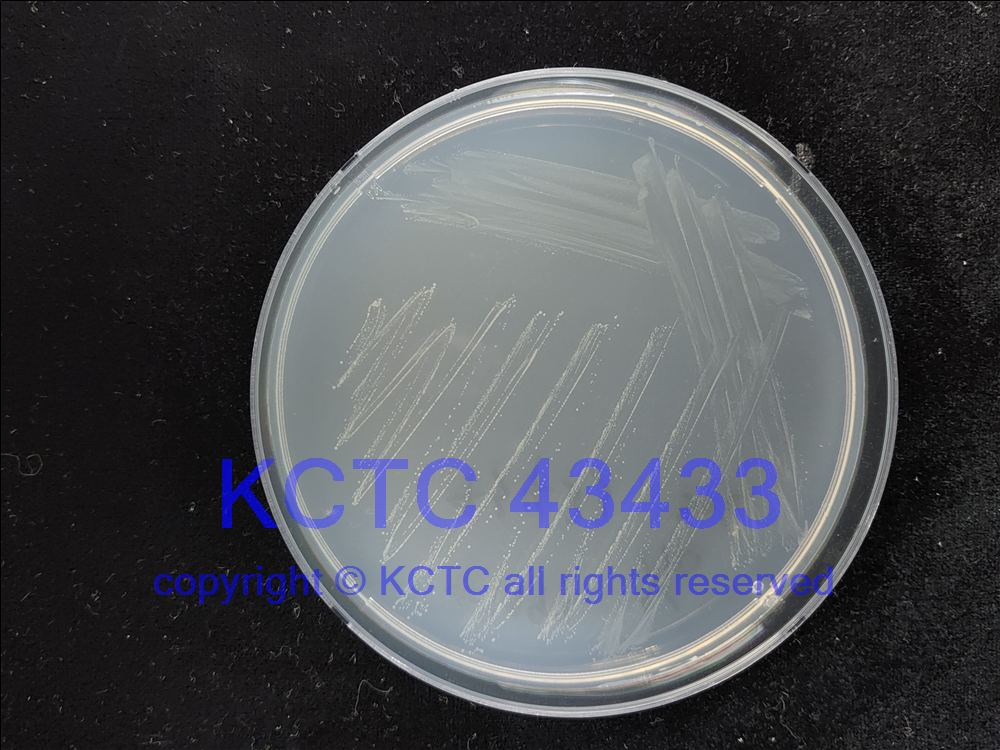

KCTC No. 43433
(KCTC Other No.)
Resource Type Bacteria
Name Trichococcus flocculiformis
Type Strain Yes
Biosafty Level 1
LMO No
Synonym
Phylum (ex Phylum) Bacillota (Firmicutes)
Genome Information
NCBI Genome UID : GCA_900113645.1
History <- DSMZ <- G. Scheff and F. Lingens, strain Echt <- O. Salcher
Source From activated sludge, sewage plant, Echterdingen, Germany
Other Collection No. Echt, DSM [2094], ATCC [51221]
Reference 10.1007/BF00302451
KCTC Media No. KCTC media No. 98 Tryptic Soy Agar
KCTC media No. 1794 TRICHOCOCCUS MEDIUM
Oxygen Requirement Facultative Anaerobic
Temperature 25-30 ℃
pH 8.0
Incubation Time 3 d [???? ???? ????? ??, ?? ? ????? ??? ?? ?? ? ??]